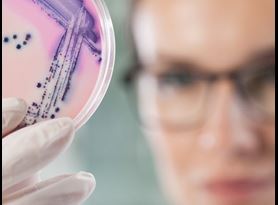

Element’s fully integrated, comprehensive contract development services support drug development programs for a wide range of biological therapeutic modalities and small molecule drugs from early discovery through manufacturing, post-approval and life cycle management.
Our experts will partner with you to support projects including antibody-drug conjugates (ADCs), peptides, monoclonal antibodies (mAbs), recombinant proteins/enzymes, protein complexes, lentivirus/adeno-associated virus gene therapies, cell therapies, oligonucleotides, other biologics including novel formats, and small molecule drugs from early discovery through manufacturing, post-approval, and life cycle management.
Accelerate speed to market and successfully navigate the entire drug development life cycle from concept to commercialization and beyond with Element’s consultative teams of regulatory and scientific experts by your side. Our best-in-class, customized solutions are tailored to overcome the challenges faced when developing complex products and unique production processes, including novel drug delivery systems (NDDS), compounds with bioavailability and permeability challenges, gastric intolerability, poor physical stability, low bioavailability, short half-life, poor solubility and difficult-to-formulate drug candidates. Our experience also extends to a wide range of complex active pharmaceutical ingredients (APIs), including sterile APIs, generics, steroids and controlled substances.
Discovery services
We have a proven track record of successfully advancing discovery programs for innovative medicines over a broad range of therapeutic areas. Our highly qualified and knowledgeable team of scientists deliver a comprehensive suite of drug discovery services including discovery chemistry, discovery biology, and synthetic and medicinal chemistry. Quickly advance from concept to candidate with our expertise in target-to-hit, hit-to-lead, and lead optimization selection with our focused libraries platform and rapid access to starting materials.
Drug substance development and manufacturing services
Our phase-appropriate drug product development services support both active pharmaceutical ingredients (APIs) and components of medical devices, from route scouting and selection, route comparison, route development, process research and development, process improvement and optimization, scale-up of new synthesis routes, GMP production, and manufacturing. Our purposefully built manufacturing sites support program needs from early development through small-scale commercialization, delivering flexible, personal, and cost-effective services (kilo lab). Additionally, our cGMP capabilities are designed for clinical trial and small-scale commercial API manufacturing. Expedite time-to-market and gain valuable strategic insights regarding the manufacturability of drug substances with the support of our experienced team who have decades of experience successfully solving the most challenging chemical development issues.
Large and small molecule drug product pre-formulation, formulation and process development services
Element is committed to providing best-in-class support to pharmaceutical and biotech companies as they navigate the identification and transformation of drug discovery candidate synthetic processes into improved, scaled-up processes. Our knowledgeable teams of formulation scientists have decades of experience guiding and accelerating the development and optimization of small and large molecule formulations for a variety of dosage forms, in addition to providing drug substances for pre-clinical trials, clinical trials and small-scale commercial manufacturing. Bring the safest, most effective parenteral, oral, topical, or ophthalmic dosage forms to market expeditiously with our deep bench of scientific and regulatory expertise, proven track record of success overcoming the most complex formulation challenges, and rigorous commitment to quality.
Clinical-scale drug product manufacturing services
Element’s flexible, phase-appropriate manufacturing services are tailored to meet the unique needs of your drug product, ensuring your manufacturing needs are met throughout the entire drug development life cycle. Our integrated global network is at the forefront of formulation and development solutions for both small molecule and biologic drugs. Our comprehensive suite of R&D engineering and clinical small-scale manufacturing solutions support engineering test studies, clinicals, and small-scale commercial manufacturing.
Chemistry, manufacturing and controls (CMC) services
A robust chemistry, manufacturing, and controls (CMC) strategy is critical throughout the product development process, from drug candidate selection through post-approval and product life cycle management. Element’s diverse team of dedicated, highly qualified and experienced scientists, technical leaders, CMC regulatory specialists, and Quality Assurance/GMP-compliance trainers support the entire product development life cycle, providing comprehensive CMC consulting and lab services, in addition to valuable industry-specific insight. Fortify the development, clinical-scale manufacturing, regulatory submissions, post-approval and life cycle management of small and large molecule drug products with our wide-ranging capabilities and deep scientific, industry and regulatory knowledge.
The Element advantage
With our demonstrated track record of success and dedicated, consultative team, you can confidently and successfully navigate the entire drug development life cycle with Element by your side, from discovery to post-approval and beyond. Our purpose-built facilities and robust, quality and compliance-driven processes have been designed to safeguard the quality and safety of your product, expediting the advancement of your therapeutic and biopharmaceutical product regulatory submissions.
To learn more about our contract development and clinical manufacturing services and solutions, contact us today.
Learn more

Pharmaceutical Pre-Formulation & Formulation Development Services
Element’s pre-formulation and formulation development services help enhance delivery performance and stability of your parenteral, ophthalmic, and topical drug products.

Parenteral Product Development and Phase I & II Clinical Manufacturing
Element is at the forefront of pharmaceutical development and manufacturing of parenteral formulations, providing specialist parenteral product development and clinical manufacturing services.

Topical Product Development and Clinical-Stage Manufacturing
Our topical drug development and clinical manufacturing services help you to formulate robust topical dosage forms, including gel, cream, lotion, ointment, suppository, and emulsion.

Chemistry, Manufacturing, and Controls (CMC) Consulting Services
We provide consulting services for Chemistry, Manufacturing, and Controls (CMC) product development in the pharmaceutical and biotechnological industries.
Microbiological Development and Quality Control Testing
Our microbiology lab provides microbiology testing services and quality control for a variety of drug products, ensuring they are safe, quality, and compliant with relevant regulatory standards.

